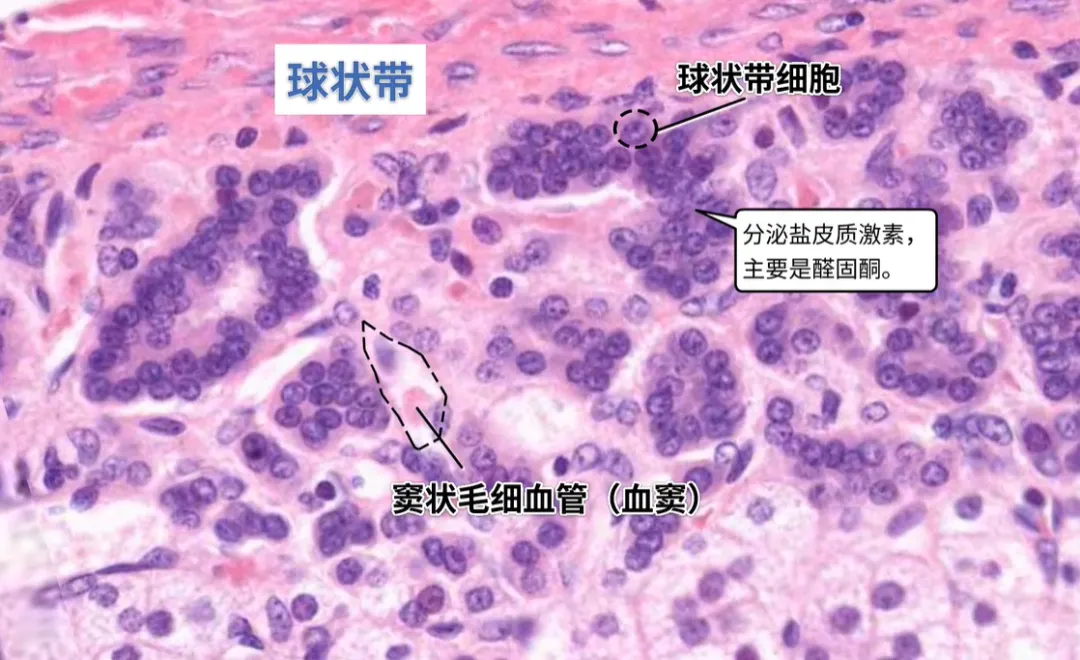
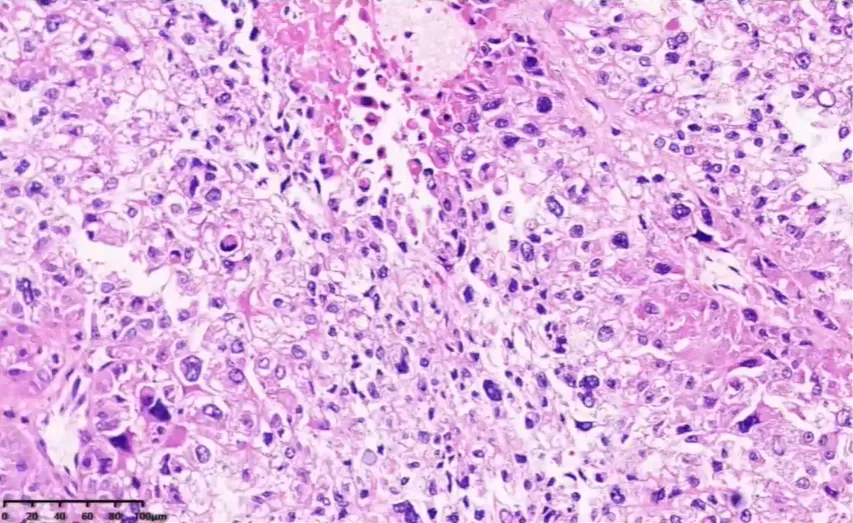
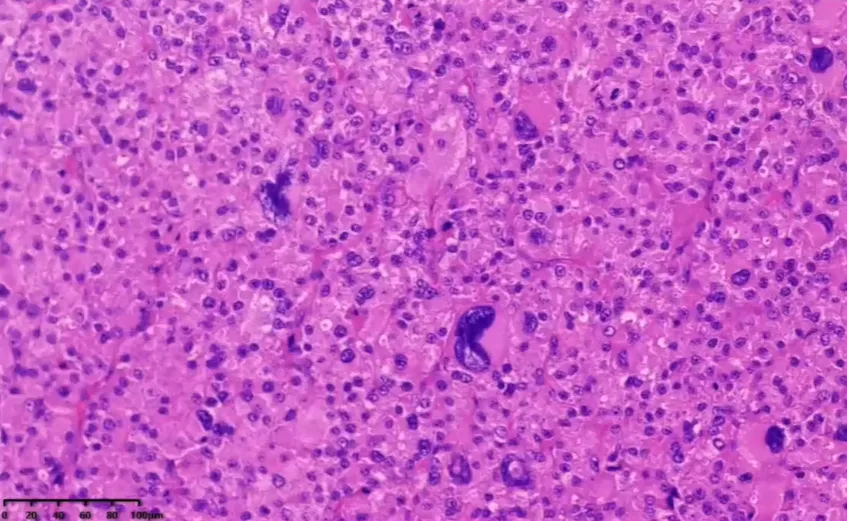

(学习笔记)肾上腺皮质癌病理诊断 - 详解
- 2026-05-17 02:32:44
1. 基本位置与形态
左右各一,位于腹膜后、肾脏上方
左侧呈新月形,右侧呈金字塔形
2. 左侧肾上腺
内侧:左侧膈脚、左膈下动脉
外侧:脾
前部:小网膜囊、胃、脾动脉、胰腺
后部:左肾
3. 右侧肾上腺
内侧:右侧膈脚、右膈下动脉
外侧:肝
前部:下腔静脉
后部:右肾

一、皮质(中胚层来源)
1. 球状带(占比 < 5%)
组织形态:细胞呈簇状、小梁状排列,核卵圆形,可见核沟
分泌激素:盐皮质激素(醛固酮)
2. 束状带(最厚,占比 70%)
组织形态:细胞呈柱状排列,核圆、居中,可见小核仁,胞浆透明
分泌激素:糖皮质激素(皮质醇)
3. 网状带(占比 25%)
组织形态:胞浆呈颗粒状、嗜酸性,紧邻髓质,细胞内含脂褐素
分泌激素:雄激素
二、髓质(神经外胚层来源)
细胞类型:嗜铬细胞
分泌激素:肾上腺素、去甲肾上腺素

正常肾上腺网状纤维染色。
网状纤维的主要成分是网状蛋白,网状纤维染色显示完整纤维结缔组织网。
Part 3肾上腺皮质癌
一、肾上腺皮质癌 - 基本特征
肾上腺位于双侧肾脏上方,结构分为皮质和髓质。
皮质癌发生于外层皮质,该部位负责分泌多种重要激素。
ICD-O 编码:8370/3
发病率:发病率低,仅为 0.7~2.0/100 万人。
高发人群:好发于儿童(4 岁)和成人(45 岁)。多发于女性。
病例性质:大多数为散发病例。
🧬遗传相关综合征:部分遗传综合征会导致肾上腺皮质癌(ACC)高发,相关综合征包括:Li-Fraumeni 综合征、Lynch 综合征、MEN1 综合征、Beckwith Wiedemann 综合征、Carney 综合征、NF1 综合征
最常见关联:Li-Fraumeni 综合征,可见于 50%~80% 的儿童 ACC 患者。约 3% 的成人 ACC 患者与 Lynch 综合征相关。
ACC 为高度恶性肿瘤,具有侵袭和转移特性。目前最好的治疗手段为根治性手术切除。但多数患者在诊断时已经有转移灶,多转移至肝、腹膜后区域淋巴结、肺及骨等部位。成人患者预后差,中位生存期为 1~2 年,而儿童患者预后相对较好。
大部分 ACC 侵袭特征明显,诊断较为明确。
临床实践中:形态学较为温和的低级别 ACC 与肾上腺皮质腺瘤(Adrenocortical adenoma, ACA)鉴别困难,准确区分肾上腺皮质肿瘤的良恶性对于临床治疗至关重要。
第 5 版分类提倡采用p53 和 β-catenin免疫组织化学染色检测预后不良分子。
分子分型:根据分子特征,将 ACC 分为低 CpG 岛甲基化表型(CpG island methylator phenotype,CIMP)和高 CIMP 两型。
低 CIMP 型罕见 TP53 或 Wnt 信号通路突变、黏附于 mRNA 表达簇,通常肿瘤更温和、无全基因组倍增。
高 CIMP 型常伴 TP53 和 Wnt 信号通路基因突变,肿瘤预后差,反复出现 CpG 岛甲基化、可能伴全基因组倍增及大量非复发性突变。
但该分型目前尚未应用于临床,癌症基因组图谱推荐含 68 个探针的甲基化检测试剂盒用于诊断 ACC,有望用于指导 ACC 临床处理。(可能在短期内推进的分子分型)
二、肾上腺皮质癌 - 病理诊断
◆ 无论是肿瘤的排列方式,还是细胞形态均与正常肾上腺皮质有较大差异。
◆ 最常见的组织结构:无显著特征的实性细胞巢被纤细的窦隙状血管分隔。
◆ 其次为宽的小梁、条带状及较大的巢状生长。有时可有细的小梁状或波形生长,但未见真正的腺管形成。宽的纤维带偶可见到。
◆ 坏死常见。
◆ 部分肿瘤偶见黏液变性。
◆ 肿瘤常侵犯被膜或大的静脉血管。
◆ 肿瘤细胞有两种形态:
类似网状带的胞质致密、嗜酸性胞质的细胞,
类似束状带的、富脂质的透明胞质的细胞。
◆ 细胞核的异型性从轻度到重度不等,有时可见高度异型性核及多核瘤巨细胞,核分裂数量多少不等。
(一)肾上腺皮质癌 WHO 5th 更新内容
组织学亚型
普通型 (conventional)
嗜酸细胞型 (oncocytic):嗜酸性细胞 > 90%,高级别核形态
黏液型 (myxoid):罕见,间质内黏液 10%-95%
肉瘤样型(sarcomatoid):极罕见,恶性度极高,骨肉瘤、软骨肉瘤、横纹肌肉瘤和 PNET 样分化肉瘤成分 > 10%
⭐肾上腺皮质肿瘤良恶性评判标准:针对肾上腺皮质肿瘤不同的组织学亚型、目标人群,引入相应的良恶性评分系统
(二)肾上腺皮质癌-普通型
第 5 版分类仍采用 Weiss 标准诊断:经典型肾上腺皮质癌
◆ 9 条诊断标准中需至少满足 3 条
◆ 网状纤维染色有助于判定肿瘤浸润与否
第 5 版分类强调血管侵犯对诊断与评估预后的影响

(二)肾上腺皮质癌-包膜、血管侵犯
◆ 第 5 版分类强调血管侵犯对诊断与评估预后的影响,有血管侵犯的 ACC 患者生存期相对较短,无论是高级别还是低级别 ACC,与甲状腺血管内癌栓判定标准一致,强调CD61免疫组织化学染色有助于识别血管侵犯部位的血小板,从而辅助明确真性血管内癌栓。
◆ 血管侵犯包括两种形式:
1. 大体观察到血管内瘤栓
2. 镜下观察到肿瘤细胞侵犯血管壁或管腔内有肿瘤细胞 / 血栓混合物

(三)Lin-Weiss-Bisceglia 评判系统 - 嗜酸细胞型
该系统是 WHO 第 5 版肾上腺皮质肿瘤分类中,针对嗜酸细胞型肾上腺皮质癌的专属良恶性评分标准,区别于经典型的 Weiss 标准,专门用于嗜酸细胞 > 90% 的肾上腺皮质肿瘤的良恶性判定。

(四)5th WHO新增 鉴别肾上腺皮质肿瘤的良恶性


(五)网状纤维染色 评判及判读
1、肾上腺皮质癌 网状纤维 - 评判标准

2、肾上腺皮质癌 网状纤维 - 判读方法
① 定量:网状纤维结构破坏判断标准:一个高倍视野(单个高倍视野 = 0.2mm²,400 倍)内未观察到连续的网状纤维或基底膜网,不连续区域至少占总观察区域的三分之一。Volante 等发现以 Weiss 评分法为基准,RA(专门用于肾上腺皮质肿瘤良恶性鉴别诊断的简化评分系统) 诊断 ACC 的敏感性和特异性均为 100%,而单用网状纤维染色诊断的敏感性和特异性分别达到了 100%、96%(一个高倍视野内存在网状纤维缺失或不连续)。
ACA 的网状纤维染色通常能勾勒出完整腺泡结构。
② 定性:网状纤维框架完整,但还有不同程度的纤维厚度不均、线条粗糙、围绕单个细胞或细胞团等,(认为网状纤维结构完整但网状纤维厚薄不均、形状不规则、伴磨损样外观且包绕单个细胞或小团细胞的现象)
应用分析:
定量改变有以下优势:定量改变更易识别,可重复性更好;
定性改变观察者间差异大,误判风险较高;
定性改变在部分 ACA 也可观察到,特异性低

网状纤维染色
(六)肾上腺皮质癌 诊断方法总结
ACC 现有多种诊断方法,包括 Weiss 评分(最广泛应用)、网状纤维法、Lin-Weiss-Bisceglia 标准、Helsinki 评分等,这些诊断方法以组织学特征为主(包括与肿瘤恶性相关的重要组织学特征:
核分裂象(通常大于 5/50HPF)、不典型核分裂象、包膜侵犯、肿瘤性坏死、血管侵犯等)。这些特征具有主观性,在不同的医生诊断时会出现不一致的情况,造成病理诊断差异,使在实际临床工作中肾上腺皮质肿瘤的良恶性诊断具有挑战性,诊断存疑时可应用多种诊断标准综合考虑。
尽管以上诊断标准内容不尽相同,但多以组织学为主,所有诊断标准均包含核分裂象计数及坏死判断。
(七)肾上腺皮质癌 免疫组化
肾上腺皮质来源标志物包括 SF-1(最常用且特异)、Calretinin、α-inhibin、MelanA 和 Syn(常用但特异性略差)。
增殖相关标记物 Ki67 在 ACC 中指数常>5%,而 ACA 则常<5%。
磷酸化组蛋白 3(Phosphohistone H3,PHH3)特异性标记核分裂象,可辅助核分裂象计数及不典型核分裂象判定。
胰岛素样生长因子 2(Insulin-like growth factor 2,IGF2):胞质阳性,80% 成人 ACC 中可见核旁 IGF2 阳性表达。
β-catenin:在 ACC 中特异性弥漫核表达。
p53核过表达(>5% 细胞阳性)支持 ACC 的诊断。
细胞色素 P450 家族 11 亚科 B 成员 1(CytochromeP450 family 11 subfamily B member 1,CYP11B1)和细胞色素 P450 家族 11 亚科 B 成员 2(Cytochrome P450 family 11 subfamily B member 2,CYP11B2)是激素标记物,分别标记肾上腺皮质束状带和球状带细胞,反映分泌皮质醇和醛固酮细胞分布情况,目前极少用于肾上腺皮质肿瘤的诊断和鉴别;研究提示 CYP11B1 在 ACC 中低水平表达。
约 3%~5% 的 ACC 有错配修复(Mismatch repair,MMR)蛋白功能缺陷。
网状纤维染色作为有效的诊断手段被纳入诊断方法。

三、肾上腺皮质癌 - 鉴别诊断
1、肾上腺皮质腺瘤:目前比较公认的是由 Weiss 等提出、由 Aubert 进行改良的组织学标准,存在 3 条及以上者,判断为恶性。
肾上腺皮质腺瘤与邻近的肾上腺组织界限清楚,轮廓光滑,无包膜,有时可形成外周纤维性假包膜。
通常由三种细胞成分不同比例混合而成,包括类似束状带的富含脂质的透明细胞、不含脂质胞质的嗜酸性类似网状带的致密细胞,以及类似于球状带的胞质空泡化的细胞。
肿瘤细胞有各种各样的排列方式,包括巢灶、条索及小梁状等,较少见的有假腺泡状伴黏液基质。
坏死及核分裂极罕见。
2、嗜铬细胞瘤:起源于肾上腺髓质,表面可覆盖一层较薄的皮质组织;肿瘤切面为红褐色,常有斑杂颜色。细胞呈器官样排列特点。免疫组化 CgA 强阳性。
3、转移性癌:常见的转移性癌有肺癌、乳腺癌、胃肠道腺癌、甲状腺癌及肾癌等。转移癌的生长方式常为巢状,实性生长或腺管状,免疫组化角蛋白强阳性,EMA 阳性。消化道腺癌常 CEA 阳性;TTF-1 常见于肺腺癌及甲状腺癌;PAX-8 可见于甲状腺癌、肾细胞癌;GATA-3 常见于乳腺癌及尿路上皮癌等。
4、恶性黑色素瘤:肾上腺原发性黑色素瘤罕见,转移性更多见,需仔细询问有无皮肤、黏膜 “痣” 切除史,仔细寻找肿瘤细胞内黑色素。免疫组化 S-100、HMB-45、Melan-A 及 Sox-10 等阳性有帮助。
5、脂肪肉瘤:肿瘤灰白或淡黄色,界限不清,浸润性生长。肿瘤细胞梭形或上皮样,仔细寻找脂肪母细胞,必要时在肿瘤边缘处、淡黄色区域多取材。免疫组化 S-100 有时脂母细胞可阳性。有条件者做 FISH 检测相关基因扩增情况。
三、儿童型肾上腺皮质癌
1、Wieneke评分系统 - 儿童型 5th WHO新增


评分≥4 分:肾上腺皮质癌 评分 = 3 分:恶性潜能不定 评分≤2 分:肾上腺皮质腺瘤
儿童肾上腺皮质肿瘤少见,良恶性鉴别诊断困难,用于成人肾上腺肿瘤诊断和预后的病理标准通常不足以预测儿童肾上腺肿瘤的生物学行为。因此,第 5 版分类根据系列研究,首次推荐采用 Wieneke 系统对其进行良恶性鉴别
儿童 ACC 与 TP53 胚系突变有关,核分裂象 > 15 个 / 4 mm² 即为高核分裂象。
2、临床特点
发病高峰:5 岁以前和青少年 相比于成人型,功能性 ACC 更常见,高达 80% 病例分泌雄激素 男性化:阴毛生长、阴茎或阴蒂增大、多毛症 少数病例表型为 Cushing 综合症
3、组织病理学
无异于成人型肾上腺皮质癌 核多形性可以更明显(出现瘤巨细胞及明显的核仁) 核分裂象更多见,儿童型 > 15/4mm²(20HPF) 良恶性评判标准有所不同 (Wieneke criteria)
4、分子遗传学
80% 的病例出现TP53 胚系突变
50%-80% 患者Li-Fraumeni syndrome(TP53 胚系突变)
遗传性 11p15 异常导致的Beckwith-Wiedemann syndrome在部分病例中具有致病意义
Part 4肾上腺皮质癌 - 病理分期与临床分期
一、肾上腺皮质癌 - 病理分期

二、肾上腺皮质癌 - 临床分期

Part 5病例分享
病例1
手术所见(2025-4-15):不整形组织一块,大小 5×3×2cm,沿多切面打开,切面可见一结节,直径 1cm,切面金黄,质中,与周围组织界尚清。

肿瘤结节状,轮廓较清楚


肿瘤细胞巢片状,分深染和淡染区。由胞质嗜酸和胞质透明2种肿瘤细胞构成。间质被纤细的窦状毛细血管分割。瘤细胞形态温和,细胞异型性小,核圆形。

MelanA阴性,α-inhibin、calretinin、syn阳性。

CGA、S-100阴性,Vimentin、AE1/AE3部分阳性。


网状纤维染色能完整显示腺泡结构

🌺 病理诊断:肾上腺皮质腺瘤。
病例2
手术所见(2024.8.8):右侧髂窝处巨大肿物约 10×9cm,灰白质硬,布满怒张血管,沿腹主动脉右后壁多发肿大淋巴结,较大者直径 3cm,且融合成团。

胞浆嗜酸或透亮,细胞异型性大,可见瘤巨细胞。

肿瘤性坏死

脉管内瘤栓




网状纤维染色。网状纤维结构破坏。厚壁不均。

🌺 病理诊断:肾上腺皮质癌。
Part 6肾上腺皮质癌 - 小结
肾上腺皮质肿瘤良恶性评价:
基于 HE 形态,结合网状纤维染色、免疫组化标记、可能的基因异常,参照 “评价标准” 综合判断。
推荐在形态学观察的基础上,多种标记物联合检测,优先使用 Ki67 指数、网状纤维染色,提高诊断的准确性。
不轻易诊断良性
◆ 嗜酸型肾上腺皮质肿瘤
◆ 查见核分裂象
◆ 出现肿瘤性凝固性坏死
疾病特征:肾上腺皮质癌是一种罕见但恶性程度高的内分泌肿瘤。
关键策略:早期诊断和根治性手术是改善患者预后的核心关键。
综合治疗:多学科协作模式,涵盖手术、米托坦、化疗及靶向治疗。
